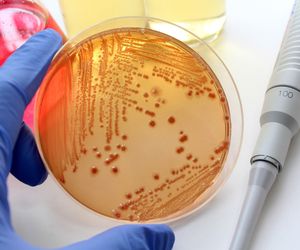

Choroby zakaźne
Choroby zakaźne to szerokie pojęcie, które obejmuje stany chorobowe wywołane przez czynniki chorobotwórcze i stanowiące zagrożenie dla zdrowia publicznego. W zależności od etiologii choroby czynnikiem powodującym przełamanie odporności organizmu mogą być grzyby, bakterie, wirusy lub toksyny. Do przeniesienia choroby zakaźnej najczęściej dochodzi w wyniku kontaktu z osobą chorą. Choroby zakaźne występują zarówno u osób dorosłych, jak i u dzieci.
Cechą charakterystyczną chorób zakaźnych jest ich szybkie rozprzestrzenianie się w populacji. Dlatego bardzo ważna jest profilaktyka zarówno indywidualna, jak i zbiorowa. Wśród sprawdzonych metod warto wymienić dbałość o higienę, przestrzeganie kalendarza szczepień (zwłaszcza u osób wyjeżdżających do egzotycznych krajów) oraz korzystanie z usług medycznych wyłącznie w placówkach służby zdrowia, które dbają o zachowanie należytej czystości sprzętu medycznego. W ujęciu społecznym istotne znaczenie ma nabycie odporności populacyjnej.
W Polsce do najczęściej występujących chorób zakaźnych należy grypa, ospa wietrzna, wirusowe zakażenie jelitowe, WZW i gruźlica. Każda z nich objawia się w inny sposób, ale nieleczone mogą stanowić zagrożenie dla zdrowia, a nawet życia.
Grypa wywoływana jest przez wirusa grypy typu A lub B. Do jej typowych objawów zalicza się wysoką temperaturę, ból głowy, stawów i mięśni oraz zmęczenie. Ospę wietrzną wywołuje wirus ospy wietrznej, ale także półpasiec. Ospa objawia się najczęściej gorączką, biegunką, ale także pojawieniem się drobnych wykwitów skórnych na całym ciele.
Wirusowe zapalenie wątroby, czyli WZW to choroba zakaźna wywoływana przez wirusy hepatotropowe. Najpopularniejsza odmiana tej choroby to WZW A, zwana inaczej chorobą brudnych rąk, która stanowi aż 59% wszystkich przypadków WZW na świecie. Do zakażenia zazwyczaj dochodzi poprzez kontakt z żywnością umytą w skażonej wodzie, ale też poprzez kontakt z zarażoną powierzchnią (np. środkach komunikacji miejskiej.
Wiele chorób zakaźnych rozwija się latami nie dając żadnych objawów, dlatego ich diagnoza może być skomplikowana.